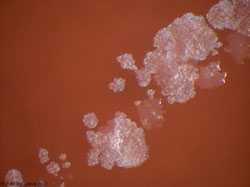
Image of buruli ulcer growing.

Signs and Symptoms
What are the signs and symptoms?
The symptoms of Buruli ulcer include:
- Swelling of the skin
- Destroyed skin and soft tissue
- One or more slow growing, generally painless ulcers
People who are sick should see a doctor and get antibiotics (medicine that can help stop the disease).
If these antibiotics are not given soon after getting sick, the disease can sometimes lead to:
- Deformity
- Functional disability (such as limited joint movement)
- Bone infection
- Secondary bacterial infection of skin ulcer lesions
- Page last reviewed: January 26, 2015
- Page last updated: January 26, 2015
- Content source:


 ShareCompartir
ShareCompartir